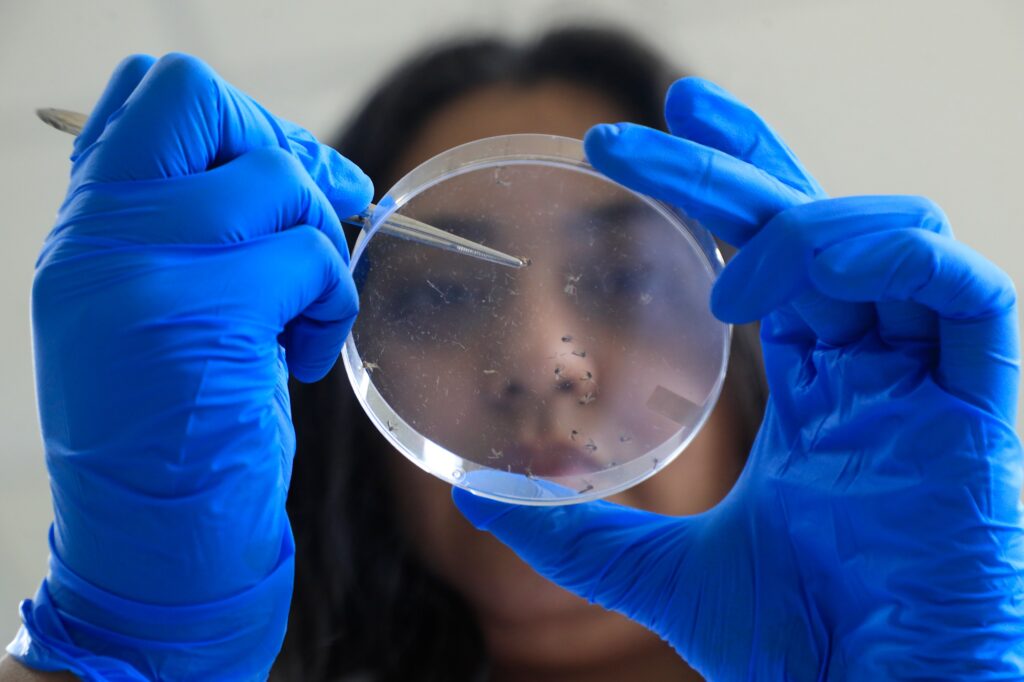

Noticias
Dictaminan a favor de declarar Día Nacional del Investigador Salvadoreño
La medida busca reconocer y visibilizar la labor de los investigadores científicos en el país
La Comisión de Niñez e Integración Social de la Asamblea Legislativa ha dictaminado a favor de declarar el 20 de septiembre de cada año como el Día Nacional del Investigador Salvadoreño. Esta medida, impulsada por el grupo parlamentario de Nuevas Ideas, tiene como objetivo reconocer la labor de los investigadores científicos en El Salvador, quienes juegan un papel crucial en la creación de conocimiento, la transferencia tecnológica y la promoción del progreso científico.
La iniciativa destaca la importancia de los investigadores en la transformación de El Salvador hacia un futuro más sostenible y equitativo, y subraya el rol que juegan en la promoción del avance científico y tecnológico, elementos esenciales para el desarrollo del país.
La diputada Lorena Fuentes expresó que esta propuesta representa un precedente importante para honrar a los investigadores que han trabajado en el anonimato, muchas veces sin recibir ningún reconocimiento. Asimismo, la medida busca inspirar a nuevas generaciones y fomentar el interés en la investigación científica entre los jóvenes salvadoreños.
“Es un precedente grande para reconocer a los investigadores científicos que han dado sus aportes en el anonimato, sin ningún reconocimiento; como para las nuevas generaciones que tengan la posibilidad de ser reconocidos con un día para ellos”, comentó la diputada.

Legal
Corte Suprema de El Salvador y Poder Judicial de Perú fortalecen cooperación en encuentro sobre extinción de dominio

Las máximas autoridades judiciales de El Salvador y Perú sostuvieron un encuentro bilateral enfocado en fortalecer la cooperación institucional y el intercambio de experiencias sobre extinción de dominio y combate al crimen organizado.
La reunión se desarrolló en San Salvador y reunió al presidente de la Corte Suprema de Justicia de El Salvador, Henry Alexander Mejía, y a la presidenta del Poder Judicial de Perú, Janet Tello Gilardi.
Además, el encuentro marcó el cierre de una pasantía especializada que abordó herramientas jurídicas relacionadas con recuperación de bienes de origen ilícito.
Magistrados analizaron criterios y experiencias legales
La actividad abrió un espacio de diálogo entre jueces y magistrados de ambas instituciones judiciales.
Por parte de El Salvador participaron el magistrado Ramón Iván García, integrante de la Sala de lo Constitucional; Alejandro Antonio Quinteros Espinoza, presidente de la Sala de lo Penal; y la magistrada Sandra Luz Chicas de Fuentes.
Durante las sesiones, los participantes intercambiaron criterios jurídicos y experiencias sobre procesos vinculados a la extinción de dominio.
Las autoridades también abordaron mecanismos utilizados para enfrentar estructuras criminales y combatir actividades relacionadas con corrupción.
Especialistas revisaron decisiones y aplicación de normas
Especialistas revisaron decisiones y aplicación de normas
La pasantía inició el 23 de junio y contó con apoyo de la Oficina de Asuntos Internacionales de Narcóticos y Aplicación de la Ley de la Embajada de Estados Unidos.
En el programa se desarrollaron conversatorios técnicos con magistrados de las Cámaras Primera y Segunda contra el Crimen Organizado.
Los participantes analizaron temas relacionados con construcción de jurisprudencia, naturaleza jurídica de la extinción de dominio y su aplicación práctica.
Asimismo, el magistrado Alejandro Antonio Quinteros presentó criterios relevantes de la Sala de lo Penal sobre esta materia.
La magistrada Sandra Luz Chicas de Fuentes expuso aspectos relacionados con recursos de casación y valoración de pruebas.
El intercambio busca reforzar mecanismos regionales
Las instituciones señalaron que la actividad busca consolidar vínculos de cooperación judicial entre ambos países.
Además, pretende ampliar el intercambio de buenas prácticas y fortalecer herramientas para recuperar activos de origen ilícito.
El proceso también apunta a actualizar marcos jurídicos y desarrollar mecanismos alineados con estándares internacionales en la lucha contra el crimen organizado.
Legal
Consejo de la Judicatura inaugura sala para simulación de audiencias judiciales

El Consejo Nacional de la Judicatura (CNJ) inauguró una Sala de Simulación de Audiencias destinada al fortalecimiento de la formación práctica de jueces y servidores del sistema judicial.
El nuevo espacio funcionará dentro de la Escuela de Capacitación Judicial “Dr. Arturo Zeledón Castrillo” y servirá para desarrollar actividades relacionadas con el estudio, análisis y práctica forense.
Las autoridades señalaron que la iniciativa busca acercar la formación académica a escenarios similares a los procesos judiciales reales.
El espacio permitirá ejercicios basados en casos prácticos
La nueva sala facilitará el desarrollo de simulaciones y ejercicios vinculados con procedimientos judiciales.
Además, los participantes podrán fortalecer habilidades relacionadas con argumentación jurídica, valoración de pruebas y dinámicas procesales.
“Esta sala se convertirá en un laboratorio de conocimiento, reflexión y crecimiento profesional; en un lugar donde la teoría y la práctica se encuentren para contribuir a la formación de servidores públicos más preparados”, dijo el presidente del pleno, Miguel Angel Calero.
Las autoridades indicaron que el proyecto pretende reforzar la preparación técnica y práctica de quienes participan en actividades de formación judicial.
La práctica mediante simulaciones permite recrear situaciones similares a las que se presentan en tribunales y audiencias.
Autoridades judiciales participaron en la apertura oficial
El acto de inauguración fue encabezado por el presidente del CNJ, y también participaron los consejeros propietarios Doris Deysi Castillo, Alcides Salvador Funes, Verónica Lissette González, Luis Alonso Ramírez, Carlos Wilfredo García y Santos Guerra.
Durante la actividad, las autoridades realizaron el acto oficial de apertura del nuevo espacio de capacitación.
Noticias
Empresa global de subastas digitales de vehículos IAA inicia operaciones en El Salvador

La compañía IAA (Insurance Auto Auctions), especializada en subastas digitales de vehículos y parte del grupo internacional RB Global, anunció el inicio de operaciones en El Salvador mediante una alianza comercial con Matus International.
La iniciativa incluye la apertura de un centro de operaciones en San Salvador. Desde ese punto, la empresa brindará asistencia a clientes interesados en buscar, ofertar y comprar vehículos a través de su plataforma internacional.
Con este movimiento, la compañía amplía su presencia en Centroamérica y fortalece su red de socios comerciales en la región.
El nuevo servicio ofrecerá apoyo durante el proceso de compra
La alianza busca facilitar el acceso a vehículos disponibles en mercados internacionales y acompañar a los usuarios durante cada etapa de adquisición.
Según la empresa, los clientes recibirán apoyo desde el registro en la plataforma hasta la participación en subastas, la logística y la entrega final de los vehículos.
Allan Matus, director ejecutivo de Matus International, indicó que la operación tendrá un componente de acompañamiento local para simplificar el proceso de compra.
La empresa señaló que el objetivo consiste en acercar servicios especializados a compradores que buscan nuevas opciones dentro del mercado automotor.
La expansión responde al crecimiento de la demanda regional
IAA explicó que el ingreso a El Salvador forma parte de una estrategia de crecimiento impulsada por el aumento de compradores en Centroamérica.
David Rymarz, vicepresidente senior y responsable de IAA Marketplace, afirmó que la empresa busca reforzar su presencia en los mercados donde operan sus clientes.
Además, señaló que la ampliación de la red comercial pretende facilitar el acceso a un inventario global de vehículos.
La empresa conecta actualmente a compradores y vendedores en más de 170 países mediante subastas y ventas digitales.
La plataforma opera con aseguradoras y grandes flotas internacionales
IAA trabaja con distintos sectores vinculados al mercado automotriz. Entre sus principales clientes vendedores figuran aseguradoras, concesionarios, empresas de alquiler y operadores de flotas.
Por otra parte, su empresa matriz, RB Global, administra mercados físicos y digitales para diversos sectores económicos.
Sus operaciones abarcan áreas como transporte comercial, construcción, minería, energía y agricultura.
La incorporación de El Salvador amplía la cobertura regional de la compañía y abre nuevas alternativas para compradores interesados en vehículos disponibles en distintos mercados internacionales.
Economía
Forbes revela la lista Iconoclast 50 de 2026 con Taylor Swift, Shohei Ohtani y líderes que marcan la economía global

Desde los estadios repletos de Taylor Swift y los récords deportivos de Shohei Ohtani hasta las decisiones financieras de Warren Buffett y los avances tecnológicos de Elon Musk, la revista Forbes presentó su lista Iconoclast 50 de 2026, una selección que reúne a las figuras con mayor capacidad para influir en la economía, la cultura y la tecnología mundial.
La edición de este año agrupa a empresarios, artistas, deportistas, inversionistas y filántropos cuyas fortunas combinadas superan los $2.5 billones. Sin embargo, la publicación señala que el criterio principal va más allá del dinero.
Forbes puso el foco en personas que han modificado industrias enteras con decisiones recientes, nuevas estrategias y proyectos capaces de generar cambios a gran escala.
La influencia ya no se mide solo por riqueza
La lista tomó como punto de partida a nombres reconocidos dentro de rankings empresariales y financieros. Después añadió un elemento adicional: el impacto actual de cada figura.
La metodología buscó identificar protagonistas con capacidad para mover mercados, transformar hábitos o cambiar el rumbo de sectores completos.
La diversidad también aparece entre los seleccionados. Diez integrantes son mujeres y cerca de una cuarta parte nació fuera del país donde desarrolló su carrera.
Además, algunos perfiles siguieron trayectorias académicas tradicionales, mientras otros construyeron su camino fuera de las aulas universitarias.
La inteligencia artificial y la tecnología ocupan el centro de la escena
La tecnología volvió a dominar una parte importante de la selección.
Sam Altman figura entre los protagonistas por el crecimiento de OpenAI y la expansión de herramientas basadas en inteligencia artificial.
También aparece Liang Wenfeng, fundador de DeepSeek, quien ganó espacio en la competencia global por el desarrollo de modelos de IA.
Mientras tanto, Elon Musk mantiene una posición central gracias a proyectos vinculados con Tesla, SpaceX y xAI.
Música, deportes y ayuda social amplían el alcance mundial
Las figuras del entretenimiento y el deporte también ocupan un espacio importante dentro del listado.
Taylor Swift aparece después de duplicar su patrimonio tras el éxito de su gira mundial y la recuperación de los derechos de sus grabaciones.
El beisbolista de los Dodgers Shohei Ohtani destaca por combinar resultados deportivos y crecimiento comercial, mientras Bad Bunny continúa ampliando su presencia global.
La filantropía también tiene un espacio relevante. Warren Buffett, MacKenzie Scott y otros nombres figuran por sus aportes económicos destinados a educación, programas sociales y proyectos comunitarios.
La edición 2026 muestra una fotografía amplia del poder actual. En ella conviven empresarios tecnológicos, artistas, deportistas y filántropos que hoy influyen en la forma en que las personas consumen, trabajan y viven.
Economía
CEPAL destaca inversión de El Salvador entre las principales fusiones y adquisiciones de América Latina en 2025

Las fusiones y adquisiciones transfronterizas en América Latina mostraron una fuerte concentración en Estados Unidos y en sectores industriales durante 2025. Sin embargo, una operación realizada desde El Salvador se ubicó entre las más relevantes del año, según un informe presentado por la Comisión Económica para América Latina y el Caribe (CEPAL).
El organismo indicó que México y Brasil lideraron las operaciones de mayor tamaño. Además, empresas de Centroamérica y el Caribe también participaron en movimientos importantes de inversión internacional.
Compra desde El Salvador ingresó al listado regional
La operación vinculada con El Salvador ocupó el noveno lugar entre las mayores adquisiciones transfronterizas de la región.
La empresa Tether Investments S.A. de C.V., con sede en El Salvador, adquirió el 32 % de la compañía canadiense Elemental Altus Royalties Corp. por 89 millones de dólares.
La empresa canadiense desarrolla actividades relacionadas con regalías y flujos de ingresos asociados principalmente al sector del oro.
Según información divulgada por Tether, la inversión forma parte de una estrategia para integrar activos físicos y digitales dentro de su ecosistema financiero.
La compañía explicó que la adquisición también busca fortalecer productos respaldados por materias primas y activos considerados de largo plazo.
EE UU mantuvo liderazgo como destino de inversiones
El informe de la CEPAL señaló que Estados Unidos concentró varias de las principales operaciones registradas durante el año.
Entre las mayores transacciones aparecieron la compra de Nordstrom por la empresa mexicana El Puerto de Liverpool por 3,100 millones de dólares y la adquisición de Harvest Hill Beverage Company por la guatemalteca Corporación Castillo Hermanos por 1,400 millones.
Además, las industrias manufactureras dominaron las operaciones. También destacaron inversiones en comercio minorista, energías renovables, infraestructura y servicios financieros.
Crecimiento regional avanzó a menor ritmo
La CEPAL informó que América Latina y el Caribe recibieron 194,233 millones de dólares en inversión extranjera directa durante 2025.
La cifra representó un crecimiento de 1.7 % respecto a 2024.
El organismo explicó que las tensiones comerciales internacionales y la incertidumbre económica global influyeron en el comportamiento de las inversiones en la región.
-

 Economíahace 6 días
Economíahace 6 díasAnuncian creación de Ciudad Portuaria San Jorge como parte del Corredor Interoceánico Guatemala
-

 Economíahace 7 días
Economíahace 7 díasFUNDEMAS y Agencia Española de Cooperación lanzan proyecto de economía circular para fortalecer el reciclaje en El Salvador
-

 Economíahace 7 días
Economíahace 7 díasGobierno de El Salvador y BID activan plan para impulsar crecimiento económico
-

 Articuloshace 7 días
Articuloshace 7 díasMonetae impulsa infraestructura digital para ampliar el acceso a la inversión en América Latina
-

 Noticiashace 7 días
Noticiashace 7 díasEE. UU. endurece postura sobre México y mantiene abierta la posibilidad de acciones militares contra cárteles
-

 Noticiashace 7 días
Noticiashace 7 díasClaves para no ser estafado durante el Mundial 2026 en compras, boletos y apuestas en línea
-

 Noticiashace 7 días
Noticiashace 7 díasDefensoría del Consumidor lanza programa para fortalecer atención y gestión de reclamos en comercios
-

 Economíahace 5 días
Economíahace 5 díasDavivienda recibe la Palma de Oro 2026 de Camarasal por su aporte al desarrollo económico de El Salvador


































